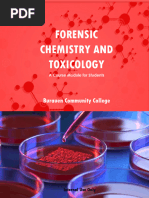

0% found this document useful (0 votes)
64 views4 pagesLecture Series
This document provides information about an introductory course on forensic science offered at Lahore University of Management Sciences. The 3 credit hour course will take place over the summer term from June 14th to July 9th and will consist of 15 lectures. It will be taught by Muhammad Zaheer and aims to discuss the scientific principles and techniques used by forensic scientists to solve criminal cases. The course objectives are to review the interdisciplinary nature of forensic science and apply various analytical techniques to evidence. Students will be evaluated based on case study reports and presentations, quizzes, class participation, and a final exam.
Uploaded by
Mohamed Ali AbdiCopyright
© © All Rights Reserved
We take content rights seriously. If you suspect this is your content, claim it here.
Available Formats
Download as PDF, TXT or read online on Scribd
0% found this document useful (0 votes)
64 views4 pagesLecture Series
This document provides information about an introductory course on forensic science offered at Lahore University of Management Sciences. The 3 credit hour course will take place over the summer term from June 14th to July 9th and will consist of 15 lectures. It will be taught by Muhammad Zaheer and aims to discuss the scientific principles and techniques used by forensic scientists to solve criminal cases. The course objectives are to review the interdisciplinary nature of forensic science and apply various analytical techniques to evidence. Students will be evaluated based on case study reports and presentations, quizzes, class participation, and a final exam.
Uploaded by
Mohamed Ali AbdiCopyright
© © All Rights Reserved
We take content rights seriously. If you suspect this is your content, claim it here.
Available Formats
Download as PDF, TXT or read online on Scribd
/ 4